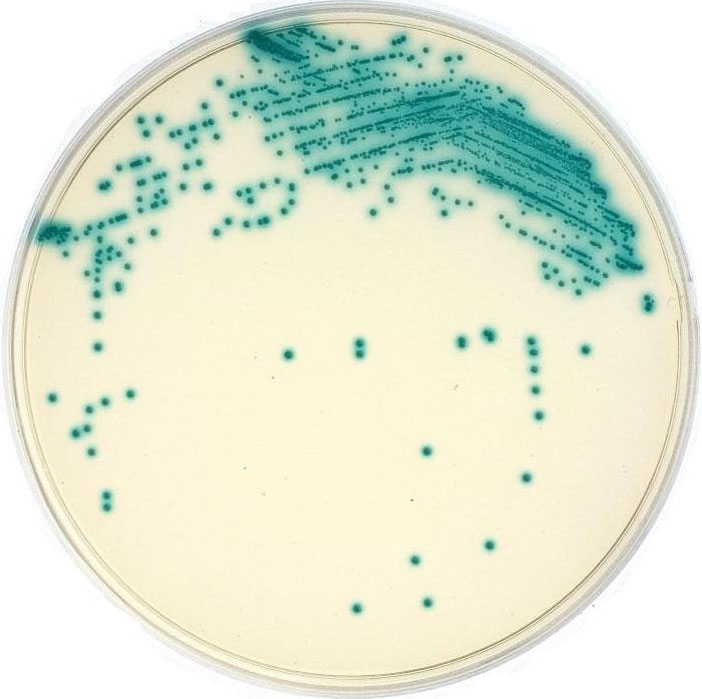

题目
实验十二 微生物大小的测定
实验十三 微生物显微镜计数法 (3学时)
详细内容
目的:学习并掌握测量微生物(酵母菌、金黄色葡萄球菌、青虫杆菌)大小的基本方法。掌握利用血球计数板计数微生物细胞数的原理和方法。
重点:学会使用测微尺和血球计数板
难点:掌握利用血球计数板计数微生物细胞数的原理
内容:
实验十二 微生物大小的测定
微生物细胞的大小是微生物基本的形态特征,也是分类鉴定的依据之一,微生物大小的测定,需要在显微镜下,借助于特殊的测量工具-----显微测微尺,显微测微尺可以用于测量微生物细胞或孢子的大小,它包括镜台测微尺和目镜测微尺两个部件。
微生物细胞的大小是微生物基本的形态特征,也是分类鉴定的依据之一,微生物大小的测定,需要在显微镜下,借助于特殊的测量工具-----显微测微尺,显微测微尺可以用于测量微生物细胞或孢子的大小,它包括镜台测微尺和目镜测微尺两个部件。
镜台测微尺是中央部分刻有精确等分线的载玻片,一般是将1mm等分为100格,每格长0.01mm(即10μm)。镜台测微尺并不直接用来测量细胞的大小,而是有用于校正目镜测微尺每格的相对长度。
目镜测微尺是一块可放入接目镜内的圆形小玻片,其中央有精确的等分刻度,有等分为50小格和100小格两种。测量时,需将其放在接目镜中的隔板上,用以测量经显微镜放大后的细胞物象。由于不同显微镜或不同的目镜和物镜组合放大倍数不同,目镜测微尺每小格所代表的实验长度也不一样。因此,用目镜测微尺测量微生物大小时,必须先用镜台测微尺进行校正,以求出该显微镜在一定放大倍数的目镜和物镜下,目镜测微尺每小格所代表的相对长度。然后根据微生物细胞相当于目镜测微尺的格数,即或计算出细胞的实际大小。
球菌用直径来表示其大小;杆菌则用宽和长的范围来表示。如金黄色葡萄球菌直径约为0.8μm,枯草芽孢杆菌大小为0.7~0.8×2~3μm。
实验十三 微生物显微镜计数法
利用血球计数板直接在显微镜下计数细胞(或孢子)的数目,是一种常用的微生物计数法。此法是将菌悬液(或孢子悬液)放在血球计数载玻片与盖玻片之间的计数室中,在显微镜下进行计数。由于载玻片上的计数室盖上盖玻片后的容积是一定的,所以可以根据在显微镜下观察到的微生物数目来计算单位体积内的微生物总数目。与其他计数法相比,它具有直观、简便和快速等优点。
利用血球计数板计数的原理是:将经过适当稀释的菌体细胞或孢子悬液,加至血球计数板的计数室中,在显微镜下逐格计数。由于计数室的容积是固定的(0.1mm3),故可将在显微镜下计得菌数(或孢子数)换算成单位体积试样中的菌数。此法所计得数值为死菌和活菌的总和,故又称为总菌计数法。
血球计数板是一块特制的载玻片,载玻片上有四条槽而构成三个平台。中间的平台较宽,其中间又被一短横槽而隔成两半,每个半边上面各刻有一个方格网。每个方格网共分九大格,其中间的一大格(又称计数室)常被用作微生物的计数。
计数室的刻度一般有两种:一种是大方格分成16个中方格,而每个中方格又分成25个小方格。另一种是一个大方格分成25个中方格,而每个中方格又分成16个小方格。但是不管计数室是哪一种构造,它们都有一个共同的特点,即每一个大方格都由16×25=400个小方格组成。
每一个大方格边长为1mm,则每一大方格面积为1mm2。盖上盖玻片后,载玻片与盖玻片之间的高度为0.1mm,所以每个计数室(大方格)的体积为0.1mm3(万分之一亳升)。
在计数的时候,通常数五个中方格的总菌数(每个中方格中数四个小方格),求得平均值。再乘上16或25就得一大方格中的总菌数,然后再换算成1毫升菌液中的总菌数。以一大方格分为25个中方格的血球计数板进行计算:
设五个中方格中的总菌数为A,菌液稀释倍数为B,那么,在一大方格中的总菌数(也即0.1立方毫米中的总菌数)为A/5×25×B。
1毫升=1立方厘米=1,000立方毫米
故:1毫升中的总菌数=A/5×25×10×1,000×B=50,000A•B(个)
同理,如果是16个中方格,设五个中方格的总菌数为A′,则1毫升菌液中的总菌数为:
A′/5×16×10×1,000×B=32,000A′•B(个)
指导:
实验十二
1.放置目镜测微尺
取出接目镜,把目镜上的透镜旋下,将目镜测微尺刻度面朝下放在目镜镜筒风的隔板上,然后旋上目镜透镜,再将目镜插入镜筒内。
2.放置镜台测微尺
将镜台测微尺刻度面朝上放在镜台上,通过调焦看清镜台测微尺的刻度。
3.校准目镜测微尺的长度
先用低倍镜观察,将镜台测微尺有刻度的部分移至视野中央,调节焦距,当清晰地看到镜台测微尺的刻度后,转动目镜,使目镜测微尺的刻度与镜台测微尺的刻度平行。移动推动器,使目镜测微尺的0点与镜台测微尺的一条刻线重合,然后于另一端找重合线,计算两端重合线之间目镜测微尺和镜台测微尺各有多少格。
用同样的方法换成高倍镜和油镜进行校正,分别测出在高倍镜和油镜下,两重合线之间两尺分别的占的格数。
注意:观察时光线不宜过强,否则难以找到镜台测微尺的刻度;换高倍镜和油镜校正时,务必十分细心,防止接物镜压坏镜台测微尺和损坏镜头。
4.计算
由于已知镜台测微尺每格长10μm,根据下列公式即可分别计算出在不同放大倍数下,目镜测微尺每格所代表的长度。
两重合线间镜台测微尺格数×10
目镜测微尺每格长度(μm)=-------------------------------
两重合线间目镜测微尺格数
5.菌体大小的测定

目镜测微尺校正完毕后,取下镜台测微尺,换上细菌染色制版片。先用低倍镜和高倍镜找到标本,再换油镜测定金黄色葡萄球菌的直径和青虫杆菌的宽度和长度的大小。测定是时,通过转动目镜测微尺和移动载玻片,测出细菌直径或宽和长所占目镜测微尺的格数。最后将所测得的格数乘以目镜测微尺(用油镜时)每格所代表的长度,即为该菌的实际大小。
测定酵母菌时,先将酵母菌培养物制成水浸片,然后用高倍镜测出宽和长各占目镜测微尺的格数,最后,将测得的格数乘上目镜测微尺(用高倍镜时)每格所代表的长度,即为酵母菌的实际大小。
通常测定对数生长期菌体来代表该菌的大小;可选择有代表性的3~5个细胞进行测定;细菌的大小需用油镜测定,以减少误差。
6.测定完毕
取出目镜测微尺后,将接目镜放回镜筒,再将目镜测微尺和镜台测微尺分别用擦镜纸擦试干净,放回盒内保存。
实验报告
1.将目镜测微尺校正结果填入下表:
| 接物镜 | 接物镜倍数 | 目镜测微尺格数 | 镜台测微尺格数 | 目镜测微尺每格的长度/μm |
| 低倍镜 | ||||
| 高倍镜 | ||||
| 油镜 |
2.将你所测定的各种菌的结果填入下表:
啤酒酵母
| 微生物名称 | 目镜测微尺每格代表的长度/μm | 宽 | 长 | 菌体大小范围/μm | ||
| 金黄色葡萄球菌 | 目镜测微尺格数 | 宽度/μm | 目镜测微尺格数 | 长度/μm | ||
| 青虫杆菌 | ||||||
| 啤酒酵母 | ||||||
实验十三
1.菌悬液的制备
以无菌生理盐水将啤酒酵母制成浓度适当的菌悬液。
2.镜检计数室
在加样前,先对计数板的计数室进行镜检。若有污染,则需清洗,吹干后才能进行计数。
3.加样品
将清洁干燥的血细胞计数板盖上盖玻片,再用无菌的毛细滴管将摇匀的啤酒酵母菌悬液由盖玻片边缘滴一小滴,让菌液沿缝隙靠毛细渗透作用自动进入计数室,一般计数室均能充满菌液。用镊子轻压盖玻片,以免因菌液过多将盖玻片顶起而改变了计数室的容积。静置片刻,待菌体自然沉降并稳定后,再开始计数。
注意:取样时先要摇匀菌液,加样时计数室不可有气泡产生。
4.显微镜计数
加样后静置5min,然后将血细胞计数板置于显微镜载物台上,先用低倍镜找到计数室所在位置,然后换成高倍镜进行计算。
注意:调节显微镜光线的强弱适当,对于用反光镜采光的显微镜还要注意光线不要偏向一边,否则视野中不易看清楚计数室方格线,或只见竖线或只见横线。
在计数前若发现菌液太浓或太稀,需重新调节稀释度后再计数。一般样品稀释度要求每小格内约有5~10个菌体为宜。每个计数室选5个中格(可选4个角和中央的一个中格)中的菌体进行计数。位于格线上的菌体一般只数上方和右边线上的。如遇酵母出芽,芽体大小达到母细胞的一半时,即可作为两个菌体计数。计数一个样品要从两个计数室中计得的平均值来计算样品的含菌量。
5.清洗血细胞计数板
使用完毕后,将血细胞计数板在水龙头上用水冲洗干净,切勿用硬物刷洗,洗完后自行晾干或用吹风机吹干。镜检,观察每小格内是否有残留菌体或其他沉淀物。若不干净,则必须重复洗涤至干净为止。
实验报告
将计数结果记录于下表中,A表示五个中方格中的总菌数;B表示菌液稀释倍数。
| 各中格的菌数 | A | B | 二室平均值 | 菌数/ml | |||||
| 1 | 2 | 3 | 4 | 5 | |||||
| 第一室 | |||||||||
| 第二室 | |||||||||
4.素材:
实验十二
1.菌种:金黄色葡萄球菌,青虫杆菌,啤酒酵母
2.仪器或其他用品:目镜测微尺,镜台测微尺,载玻片,盖玻片,显微镜等。
实验十三
1.菌种:啤酒酵母。
2.仪器或其他用具:血细胞计数板,显微镜,盖玻片,无菌毛细滴管。


